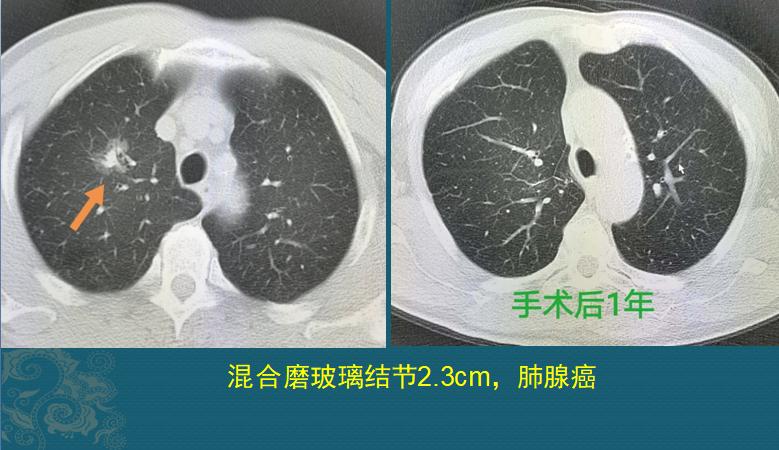
老人得了肺癌会转移吗,老人肺癌6年了

很多人说癌症治不好,治好了的都是误诊。
还有人说肺癌别动手术,手术了也会复发,也不要打化疗,会把人化死……
咱们不争辩,用事实说话,看4个病例(3个治愈,1个晚期的无法治愈),了解肺癌的治疗真相。
一.肺癌可以治愈
为了便于理解,我们把肺癌按照密度分类,分别举例,包括实性肺癌、混合磨玻璃肺癌、纯磨玻璃肺癌3种。
1.实性肺癌,可以治愈

这是一个实性肺癌,长径>3cm,左肺下叶切除+淋巴结清扫+术后辅助治疗,5年多了没有复发,以后基本就不会复发了,每年定期体检一下就好,完全恢复正常生活。
备注:医生会根据手术后的肺癌分期、病理成分分析、病人的整体状态等综合考虑,帮助确定是否采用术后辅助治疗。如果是早期、高分化、无气腔播散和淋巴结转移,很多不需要打化疗。
2.混合磨玻璃结节的肺癌,可以治愈
这是一位中年男子,体检发现右肺混合磨玻璃结节,长径2.3cm,外围是一圈半透明的磨玻璃影,边界清晰,内部有不规则实性成分,实性区域最长径约1.5cm,没有远处转移,手术病理是浸润性肺腺癌,术后1年复查恢复很好,仅残留少量胸膜肥厚,对肺功能没有影响。
备注:这种边界清晰的混合磨玻璃结节很常见,诊断不难,随着螺旋CT筛查的普及,大量此类病人被发现,并手术治愈。一般到了这种程度就不宜随访观察了,因为此时癌细胞已经具备了转移扩散的能力,有可能在数月至数年时间内发生淋巴结转移或远处转移,常见的是脑转移、骨转移、肾上腺转移、肝转移等。
3.纯磨玻璃结节的肺癌,可以治愈

这位女士是糖尿病并发症住院,胸部检查发现纯磨玻璃结节1.3cm,CT值-650HU(CT值反映结节的密度,空气是-1000HU,水是0HU)随访观察3个月没有消失,也没有进展,还可以继续观察。
考虑到长期存在的磨玻璃结节,恶性可能大,且结节直径超过1.0cm,她选择手术切除,病理是原位腺癌。
备注:原位腺癌和微浸润腺癌5年生存率接近100%,不需要后续治疗,不转移,切除后不复发。
上述3类病例说明:肺癌及时发现可以治愈!
实性、混磨、纯磨,哪种肺结节进展更快?
上面这3种不同密度的肺癌生长速度不一致,都可以生长很快,也都可以像蜗牛一样缓缓进展,但总体来说,实性肺结节要更警惕!
我们举个例子,大家看一下就能明白为何医生更重视实性结节。
下图是一位70岁老人,不知什么原因被癌细胞盯上了,双肺总共长了5个肺癌,实性、混磨、纯磨的都有:

双肺多原发肺癌
图片中1、5号病灶为实性结节,2号病灶为混合磨玻璃结节,3号病灶为囊腔样肺癌,4号病灶为纯磨玻璃结节。
这位病人很不幸,长了5个教科书式的肺癌病灶,其中最可怕的是1号、5号病灶,表现为不规则的实性肺结节,贴近胸膜,比较容易沿着胸膜丰富的脉管系统(主要是淋巴管)发生早期转移扩散。而磨玻璃结节多为惰性病灶,囊腔样肺癌及时发现,手术效果也很好。
事实上,老人也的确是已经发生颈部淋巴结转移,失去手术机会了。
老人拒绝了规范治疗,回家了。4个月后回来复查,1号和5号病灶增大了:

尤其是1号病灶,进入加速生长期了,4个月时间从3.5cm增大到4.6cm,提示癌细胞的繁殖速度非常快,非常凶狠。我们把1号病灶放大对比一下看:

箭头所示,是实性肺癌牵拉胸膜形成的胸膜凹陷征(从胸壁向肺内凹陷),呈喇叭口状,提示癌细胞侵犯胸膜,这是癌细胞的扩散途径之一,老人的颈部淋巴结转移,应该就是顺着这里扩散过去的。
所以对于大于8mm的实性不规则结节,靠近外围贴近胸膜时(靠近外周间质),或者靠近肺门大血管时(靠近中轴间质),要更积极一点对待,可以采取增强CT、经皮肺穿刺,甚至PET-CT等手段进一步排查,如果提示恶性,要及时手术处理,不要错过窗口期造成遗憾。

而对于磨玻璃结节、比较小的混合磨玻璃结节和囊腔样病灶,可以先随访观察,发现有增大再手术一般也可以,因为这3类病灶相对比较惰性,有比较长的窗口期。如上图前两个病灶需要尽快手术,而右边这个纯磨玻璃结节可以先观察,大多数是惰性病灶。
下图这位中年女性,左肺纯磨玻璃结节6mm,随访3次CT,缓慢增大到超过1cm,这个时候就需要手术切除了:

尤其是对于长期稳定的纯磨玻璃结节,不着急手术,过些年一定会有更好的治疗方法出现,对身体损伤更少。
攻克癌症不能争一夕之功,要遵循先治愈早期和一部分中期,让更多的中晚期长期带瘤生存,最终让绝大部分晚期病人都在可以承受的范围内,实现10年以上甚至几十年的生存期,到那时候,癌症就不算不治之症了。而重视定期健康体检,有助于我们在早期发现肺癌,抓住根治机会。
我是影像科豪大夫,分享小病例,传递正能量,欢迎批评指正!
以上内容仅供参考,每个人情况都不同,要灵活运用。

#谣零零计划#